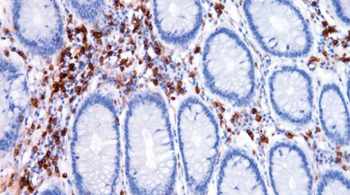
Annexin A1

You have no items in your shopping cart.
Search results for: 'ANXA1'
- Recombinant Human ANXA1 [orb1098693]
ELISA, WB
Greater than 90% by SDS-PAGE gel analyses
56.5 kDa
E.Coli
1 mg, 200 μg, 100 μg, 50 μg - Human ANXA1 ELISA Kit [orb406837]
Human
0.312 ng/mL-20 ng/mL
0.078 ng/mL
24 T, 10 x 96 T, 48 T, 96 T, 5 x 96 T - Mouse ANXA1 ELISA Kit [orb407762]
Mouse
15.6 ng/ml - 1000 ng/ml
3.9 ng/ml
10 x 96 T, 48 T, 24 T, 96 T, 5 x 96 T - Annexin I (N146) polyclonal antibody [orb644028]
IHC
Human, Mouse, Rat
Rabbit
Polyclonal
Unconjugated
200 μl, 25 μl, 100 μl, 50 μl - [KO Validated] ANXA1 polyclonal antibody [orb645677]
IF, IHC, WB
Human, Mouse, Rat
Rabbit
Polyclonal
Unconjugated
200 μl, 100 μl, 50 μl - Recombinant Human Annexin A1/ANXA1 Protein, No Tag [orb1552930]
≥90% as determined by SDS-PAGE
This protein contains the human ANXA1(Ala2-Asn346) was fused without Tag and expressed in E. coli.
50 μg, 100 μg - Annexin A1 (5E4D8) Mouse mAb [orb1563161]
WB
Human, Monkey, Mouse, Rat
Monoclonal
Unconjugated
100 μl, 50 μl, 20 μl